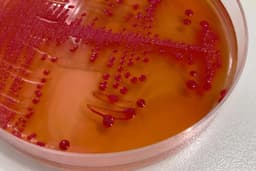
article image

Home / Health / Wales Festival Outbreak: E. coli Infection Confirmed
Wales Festival Outbreak: E. coli Infection Confirmed
26 Nov
Summary
- Several attendees contracted O26 Shiga toxin-producing E. coli after a festival.
- Public Health Wales declared an outbreak due to genomically linked cases.
- The infection can cause severe bloody diarrhea and potentially life-threatening complications.

An outbreak of the O26 Shiga toxin-producing E. coli (STEC) bacterial infection has been declared following the Big Tribute festival in Aberystwyth, Wales. Several attendees, who visited the festival between August 22 and 24 this year, have been confirmed to have contracted the illness. Public Health Wales, in collaboration with local health authorities, is investigating the source of the infection.
The outbreak was officially declared due to cases being genomically linked, a routine public health measure indicating a potential cluster. STEC is known for causing severe bloody diarrhea and can lead to serious complications, including the life-threatening Hemolytic Uremic Syndrome (HUS) which can affect the kidneys, particularly in young children, the elderly, and those with weakened immune systems.